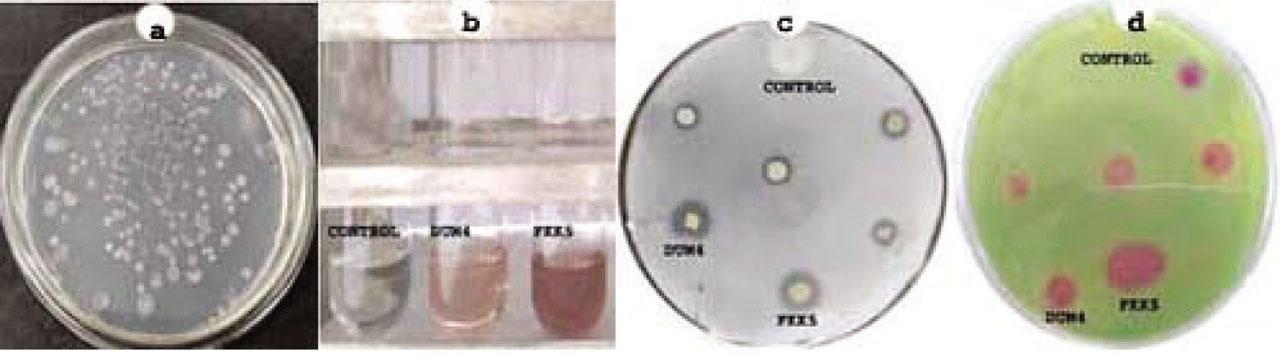

Figure 1

Figure 2
Figure 3

Figure 4

Effect of native and non-native bioinocula priming on important growth characteristics (mean ± SE, n = 3) of little millet at the harvestTabelle 3_ Einfluss des Primings von nativen und nicht nativem Bioinokulen auf wichtige Wachstumsmerkmale (Mittelwert ± SE, n = 3) von Hirse bei der Ernte
| Treatment | Root length (cm) | Root dry weight (g) | Total plant biomass (g) | Seed weight per plant (g) |
|---|---|---|---|---|
| Non-inoculated | 10.30 ± 1.27a | 0.163 ± 0.02a | 1.01 ± 0.07a | 0.360 ± 0.01a |
| Azotobacter chroococcum | 12.90 ± 0.47b | 0.197 ± 0.01b | 1.19 ± 0.01b | 0.433 ± 0.03b |
| FKK5 | 13.60 ± 0.55c | 0.206 ± 0.01c | 1.24 ± 0.06d | 0.460 ± 0.02d |
| DUM4 | 17.00 ± 1.82d | 0.279 ± 0.01d | 1.22 ± 0.03c | 0.449 ± 0.01c |
| LSD (p ≤ 0.05) | 3.21 | 0.05 | 0.07 | 0.08 |
Effect of native and non-native bioinocula priming on important growth characteristics (mean ± SE, n = 3) of little millet after 85 days of sowing before harvest in pot trialsTabelle 2_ Wirkung von Priming nativer und nicht nativer Bioinokula auf wichtige Wachstumsmerkmale (Mittelwert ± SE, n = 3) von Hirse nach 85 Tagen Aussaat vor der Ernte in Topfversuchen
| Treatment Length | Plant height (cm) | Stem diameter (mm) | No. of leaves | No. of tillers (per plant) | Panicle length (cm) |
|---|---|---|---|---|---|
| Non-inoculated | 62.5±2.47b | 1.96 ± 0.13a | 09.66 ± 1.20a | 3.66± 0.33a | 11.33 ± 0.52a |
| Azotobacter chroococcum | 57.6 ± 2.04a | 2.66 ± 0.14b | 14.66 ± 1.45b | 4.33 ± 0.33b | 11.66 ± 0.29b |
| FKK5 | 69.0 ± 2.17c | 2.93 ± 0.17d | 15.40 ± 1.76c | 4.66 ± 0.33d | 13.23 ± 0.52d |
| DUM4 | 72.0 ± 2.62d | 2.76 ± 0.19c | 17.00 ± 1.15d | 4.53 ± 0.33c | 13.10 ± 0.64c |
| LSD (p ≤ 0.05) | 6.16 | 0.44 | 4.04 | 1.38 | 1.54 |
Priming effect of native and non-native bioinocula on grain and biomass yield enhancement (IE) (mean ± SE, n = 3)Tabelle 4_ Priming-Effekt von nativen und nicht nativem Bioinokula auf Getreide- und Biomasseertragssteigerung (IE) (Mittelwert ± SE, n = 3)
| Inoculum | Grain (seed) yield enhancement (%) | Total biomass yield enhancement (%) |
|---|---|---|
| FKK5 | 28.14 ± 8.93c | 23.08 ± 2.23c |
| DUM4 | 24.72 ± 3.62b | 21.87 ± 5.58b |
| Azotobacter chroococcum | 20.43 ± 9.78a | 19.09 ± 9.34a |
Selective morpho-physiological characteristics of the potential isolatesTabelle 5_ Selektive morpho-physiologische Eigenschaften der potentiellen Isolate
| Character | Azotobacter chroococcum 5576 | FKK5 | DUM4 |
|---|---|---|---|
| Gram reaction | − | − | − |
| Cyst formation | + | − | − |
| Pigmentation | Brown | Brown | Brown |
| Motility | + | + | + |
| IAA production | + | + | + |
| NH3 production | + | + | + |
| Starch formation | + | + | + |
| Urease activity | + | + | + |
| Catalase activity | + | + | + |
| Oxidase activity | + | + | + |
| Growth on sucrose | + | + | + |
| Growth on maltose | + | + | + |
| Growth on mannitol | + | + | − |
| Growth on citrate | + | + | + |
| KOH | + | + | + |
Chemical characteristics of the experimental soilTabelle 1_ Chemische Eigenschaften des Versuchsbodens
| Site | pH | EC (ds per m) | Organic carbon (%) | Nitrogen (%) | Phosphorus (kg per ha) | Potassium (kg per ha) |
|---|---|---|---|---|---|---|
| Tamia | 6.9 | 0.53 | 0.91 | 0.154 | 14.71 | 190.11 |